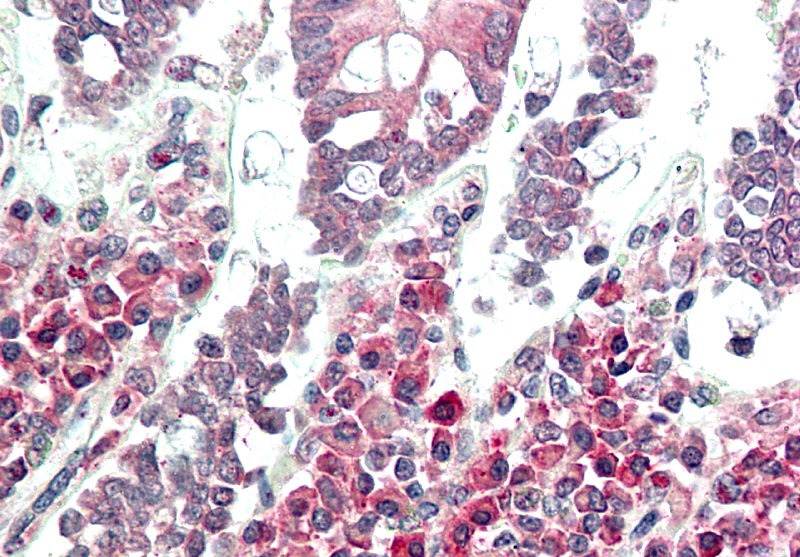

Monoclonal Antibody to TLR2 (Clone: ABM3A87)
Catalogue Number: 10-3026-ABO
| Manufacturer: | Abeomics |
| Type: | Monoclonal Primary Antibody - Unconjugated |
| Alias: | TLR2||TIL4 |
| Shipping Condition: | Blue Ice |
| Storage Condition: | 2-8°C |
| Unit(s): | 100 ug, 25 ug |
| Host name: | Mouse |
| Clone: | ABM3A87 |
| Isotype: | IgG1, kappa |
| Immunogen: | A partial length recombinant TLR2 protein (amino acids 180-420) was used as the immunogen for this antibody. |
| Application: | FACS, IF, WB, IHC |
Description
Description: TLR2 (Toll-Like Receptors 2) is a member of the TLR (Toll-like receptor) family that plays a fundamental role in pathogen recognition and activation of innate immunity. TLR2 forms heterodimers with TLR1 and TLR6, which is the initial step in a cascade of events leading to significant innate immune responses, development of adaptive immunity to pathogens and protection from immune sequelae related to infection with these pathogens. TLR2 also interacts with a large number of non-TLR molecules, allowing for recognition of a great number and variety of PAMPs (pathogen-associated molecular patterns). TLR2 expression has been detected in immune cells, endothelial, and epithelial cells.
Additional Text
Gene Name
TLR2
Gene ID
7097
Purification
Protein G purified
Uniprot ID
O60603
Antibody Clonality
Monoclonal
Application Notes
Western blot analysis: 2-4 µg/ml, FACS analysis: 0.5 µg/10^6 cells, Immunohistochemical analysis: 5 µg/ml